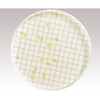

| 商品ラインアップ |
メーカー品番
|
数量
|
販売価格
|
カート |
|---|---|---|---|---|
|
|
MHA000P2T
|
1箱(50枚)
|
¥21,213
(税込)
|
¥21,213 (税込) |
|
|
PD20047S0
|
1箱(150個)
|
¥19,646
(税込)
|
¥19,646 (税込) |
共通の商品仕様 (各商品の仕様は、商品詳細ページでご確認ください)
各商品の仕様は、商品詳細ページでご確認ください
|